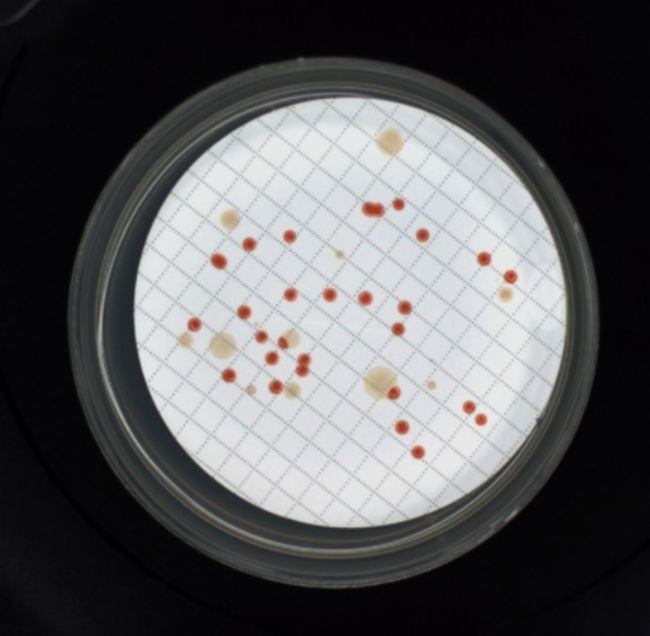

RAYPA培養基自動制備分裝儀應用案例:生活飲用水總大腸菌群檢測
方案摘要:依據 GB 5749《生活飲用水衛生標準》檢測水樣中大腸菌群(標準為不得檢出)。本方案利用濾膜法過濾法,將濾膜放置在品紅亞硫酸鈉培養基培養后計數,達到檢測出生活飲用水中的總大腸菌群數量。培養基自動制備分裝儀通過選擇性培養基精準配制、無菌流體控制、自動化流程管理等技術原理,解決了生活飲用水大腸菌群檢測中手工操作的效率低、誤差大、安全性不足等問題,為水質微生物檢測的標準化和智能化提供了關鍵技術支撐,尤其適用于大規模水樣的快速篩查與質量監控。

方案詳情:
一、實驗原理
通過自動培養皿分裝儀完成選擇性培養基的分裝,使用孔徑為 0.45μm 的微孔濾膜對水樣進行過濾,過濾后將濾膜貼附于選擇性培養基上進行培養,待形成典型菌落后,使用自動菌落計數儀對總大腸菌群數量進行快速計數。

二、實驗準備
1、培養基和試劑
① 品紅亞硫酸鈉培養基
② 乳糖蛋白胨培養液

2、儀器與設備
① 過濾設備:配備濾器和抽濾裝置。
② 濾膜:孔徑0.45um。
③ 無齒鑷子。
④ 恒溫培養箱。
⑤ 自動培養皿分裝儀 fluidot FDT-MF80。
⑥ 自動菌落計數儀SHASHIN KAGAKU,PSF-1100。
⑦ RAYPA培養基自動制備分裝儀。

三、實驗步驟
1、濾膜滅菌:將濾膜放大燒杯中,加入純水,置于沸水浴中煮滅菌3次,每次15min。前兩次煮沸后需更換純水洗滌2-3次,以除去殘留溶劑,或使用符合要求的一次性無菌濾膜。
2、濾器滅菌。用點燃的酒精棉球火焰滅菌。也可用高壓蒸收滅菌器121℃高壓蒸汽滅菌20 min。
3、用鑷子夾濾膜邊緣部分、將粗糙面向上,貼放在已滅菌的濾床上,固定好濾器,將100 mL水樣(如水樣含菌數較多,,可減少過濾水樣量,或將水樣稀釋)注入濾器中,打開濾器閥門,-5.07 x10'Pa(-0.5大氣壓)下抽濾。
4、過濾完水樣后,再抽氣約5S,關上濾器閥門,取下濾器,用鑷子夾取濾膜邊緣部分,移放在品紅亞硫酸鈉培養基上,濾膜截留細菌面向上,濾膜應與培養基完全貼緊,兩者間不應留有氣泡,然后將平皿倒置,放入36℃±1℃恒溫箱內培養24h±2h。

四、實驗數據處理
1、挑取紫紅色且具有金屬光澤的菌落、深紅色不帶或略帶金屬光澤的菌落和淡紅中心色較深的菌落進行革蘭氏染色、鏡檢。
2、凡革蘭氏染色為陰性的無芽孢桿菌,再接種乳糖蛋白胨培養液,于31℃±1℃培養24h±2h,有產酸產氣者,則判定為總大腸菌群陽性。

按公式(1)計算濾膜上生長的總大腸菌群數,以每100 mL水樣中的總大腸菌群菌落數(CFU/100ml)報告結果。



方案詳情:
一、實驗原理
通過自動培養皿分裝儀完成選擇性培養基的分裝,使用孔徑為 0.45μm 的微孔濾膜對水樣進行過濾,過濾后將濾膜貼附于選擇性培養基上進行培養,待形成典型菌落后,使用自動菌落計數儀對總大腸菌群數量進行快速計數。

二、實驗準備
1、培養基和試劑
① 品紅亞硫酸鈉培養基
② 乳糖蛋白胨培養液

2、儀器與設備
① 過濾設備:配備濾器和抽濾裝置。
② 濾膜:孔徑0.45um。
③ 無齒鑷子。
④ 恒溫培養箱。
⑤ 自動培養皿分裝儀 fluidot FDT-MF80。
⑥ 自動菌落計數儀SHASHIN KAGAKU,PSF-1100。
⑦ RAYPA培養基自動制備分裝儀。

三、實驗步驟
1、濾膜滅菌:將濾膜放大燒杯中,加入純水,置于沸水浴中煮滅菌3次,每次15min。前兩次煮沸后需更換純水洗滌2-3次,以除去殘留溶劑,或使用符合要求的一次性無菌濾膜。
2、濾器滅菌。用點燃的酒精棉球火焰滅菌。也可用高壓蒸收滅菌器121℃高壓蒸汽滅菌20 min。
3、用鑷子夾濾膜邊緣部分、將粗糙面向上,貼放在已滅菌的濾床上,固定好濾器,將100 mL水樣(如水樣含菌數較多,,可減少過濾水樣量,或將水樣稀釋)注入濾器中,打開濾器閥門,-5.07 x10'Pa(-0.5大氣壓)下抽濾。
4、過濾完水樣后,再抽氣約5S,關上濾器閥門,取下濾器,用鑷子夾取濾膜邊緣部分,移放在品紅亞硫酸鈉培養基上,濾膜截留細菌面向上,濾膜應與培養基完全貼緊,兩者間不應留有氣泡,然后將平皿倒置,放入36℃±1℃恒溫箱內培養24h±2h。

四、實驗數據處理
1、挑取紫紅色且具有金屬光澤的菌落、深紅色不帶或略帶金屬光澤的菌落和淡紅中心色較深的菌落進行革蘭氏染色、鏡檢。
2、凡革蘭氏染色為陰性的無芽孢桿菌,再接種乳糖蛋白胨培養液,于31℃±1℃培養24h±2h,有產酸產氣者,則判定為總大腸菌群陽性。
按公式(1)計算濾膜上生長的總大腸菌群數,以每100 mL水樣中的總大腸菌群菌落數(CFU/100ml)報告結果。


Copyright(C) 1998-2025 生物器材網 電話:021-64166852;13621656896 E-mail:info@bio-equip.com






